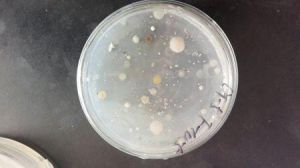
小菌落

小菌落
科技名詞定義
中文名稱:小菌落英文名稱:microcolony
定義:細菌繁殖早期或較難培養的細菌在固相載體上所形成的僅能用顯微鏡觀察到的微小菌落。
套用學科:海洋科技(一級學科);海洋科學(二級學科);海洋生物學(三級學科)
海洋學及其相關知識
| 海洋科學是研究海洋的自然現象、性質及其變化規律,以及與開發利用海洋有關的知識體系。下面讓我們來完善與海洋學相關的詞條,以此來更加深入的了解海洋學的相關知識。 |
細菌繁殖早期或較難培養的細菌在固相載體上所形成的僅能用顯微鏡觀察到的微小菌落。
中文名稱:小菌落英文名稱:microcolony
定義:細菌繁殖早期或較難培養的細菌在固相載體上所形成的僅能用顯微鏡觀察到的微小菌落。
套用學科:海洋科技(一級學科);海洋科學(二級學科);海洋生物學(三級學科)
| 海洋科學是研究海洋的自然現象、性質及其變化規律,以及與開發利用海洋有關的知識體系。下面讓我們來完善與海洋學相關的詞條,以此來更加深入的了解海洋學的相關知識。 |
